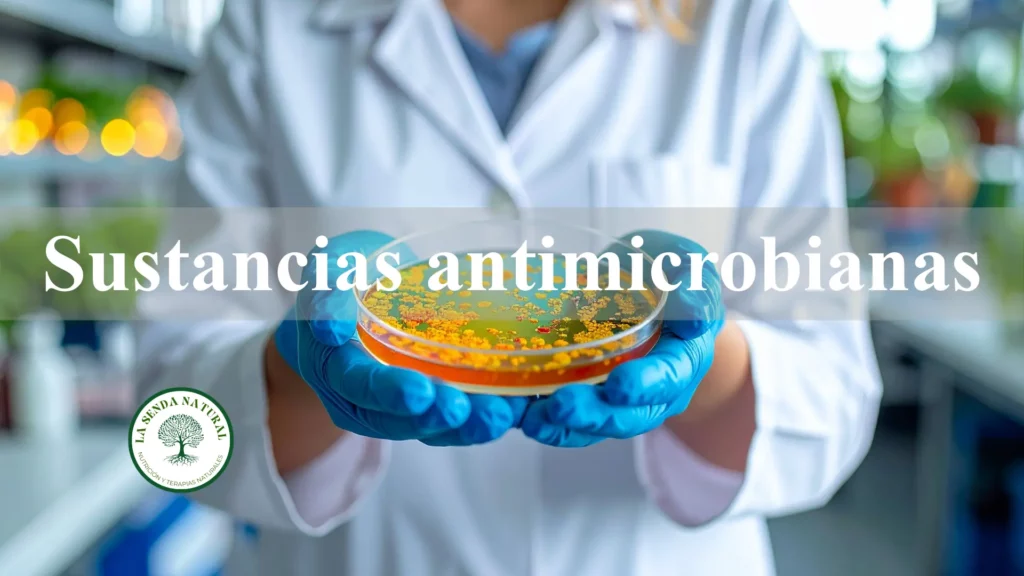
Sustancias antimicrobianas

Tribulus Terrestris
Tribulus Terrestris Gokshura Historia del Tribulus Terrestris El Tribulus Terrestris pertenece a la familia de las Zigofilaceas (Zygophyllaceae) son unas 20 especies en el mundo, pero sólo tres son comunes en la India (Tribulus terrestris, cistoides y alatis). Su distribución es amplia se encuentra en zonas subtropicales, mediterráneas y desérticas de todo el mundo (India, […]
Pseudomonas

Pseudomonas Las Pseudomonas se encuentran entre las bacterias G- psicrótrofas que se pueden multiplicar en los principales grupos de alimentos, únicamente ciertos géneros y especies ejercen una influencia real en su calidad durante su conservación. Las bacterias psicrótrofas predominantes en los productos cárnicos son las Pseudomonas. El grupo bacteriano responsable de las alteraciones de los […]
Triphala
Triphala El tesoro del Ayurveda Historia de Triphala En la medicina ayurvédica Triphala hace referencia a un preparado de plantas que está formado por 3 plantas, ya que la palabra tripala deriva del sánscrito y significa (tri= tres y Phala = fruta). Este trío de plantas está formado por tres especies de plantas la Emblica […]
Sustancias anti microbianas
Sustancias anti microbianas Algunos alimentos contienen sustancias que poseen actividad antimicrobiana, algunas especies de plantas contienen aceites esenciales con notable poder antimicrobiano. Ejemplo: eugenol en el clavo, la alicina en el ajo, aldehído cinámico y eugenol en la canela, el timol en la salvia, y carvacrol y timol en el orégano. Los huevos contienen lisozima, […]
PROBIÓTICOS Y PREBIÓTICOS

PROBIÓTICOS Y PREBIÓTICOS 1. Flora normal del ser humano Desde las primeras horas de vida, el hombre y todos los animales son colonizados por microorganismos, y algunos de ellos vivirán en simbiosis permanente con su huésped en la piel, el tracto digestivo, las vías respiratorias altas, los oídos y en otros muchos tejidos, constituyéndose la […]
OBESOGENOS-2

OBESOGENOS-2 Existen más de 500.000 moléculas químicas usadas, pero sólo cerca de 800 se han considerado como disruptores endocrinos y posibles obesógenos. Los obesógenos más estudiados son: OBESOGENOS-2 MÁS COMUNES EL TRIBULTILESTANO (TBT) Durante mucho tiempo se utilizó como biocida en pinturas de barcos, se ha comprobado que podía inducir masculinización en las hembras de […]
Conceptos básicos del Ayurveda-2
Conceptos básicos del Ayurveda-2 MALA (Acumulación de toxinas) El concepto Mala hace referencia a los productos de deshecho de los procesos naturales de nuestro organismo, por lo general se crean dos tipos de Mala: Ahara Mala (deshechos provenientes de la comida) Dhatu Mala (deshechos provenientes de los tejidos) Los primeros incluyen las heces (Purisha) la […]
OBESOGENOS

OBESOGENOS INTRODUCCION La obesidad ha alcanzado unos niveles mundiales de pandemia, aunque la realidad demuestra que esta incidencia ha aumenta de forma exponencial en las últimas cinco décadas. Un ejemplo de esta evolución es la sociedad americana que en las últimas décadas ha incrementado los niveles de obesidad a todos los niveles tanto en la […]
DISRUPTORES ENDOCRINOS

DISRUPTORES ENDOCRINOS QUE SON LOS DISRUPTORES ENDOCRINOS Los disruptores endocrinos son moléculas químicas que pueden interferir con nuestro sistema endocrino. Nuestro sistema endocrino segrega hormonas a través de las glándulas de nuestro cuerpo, que controlan procesos como el hambre, la reproducción, el metabolismo. Los disruptores endocrinos, pueden interferir con este proceso de señalización hormonal, activando […]
BENEFICIOS DE LOS MICROORGANISMOS-1

BENEFICIOS DE LOS MICROORGANISMOS-1 EL PAPEL BENEFICIOSO DE LOS MICROORGANISMO EN LOS ALIMENTOS Particularidades de los microorganismos MICROBIOLOGIA Ciencia que se encarga del estudio de los microorganismos (Hongos, Bacterias y Virus). Los microorganismos se encuentran en cualquier lugar que no esté bajo condiciones de esterilidad. Se encuentran en el aire, agua, suelo y cualquier objeto […]